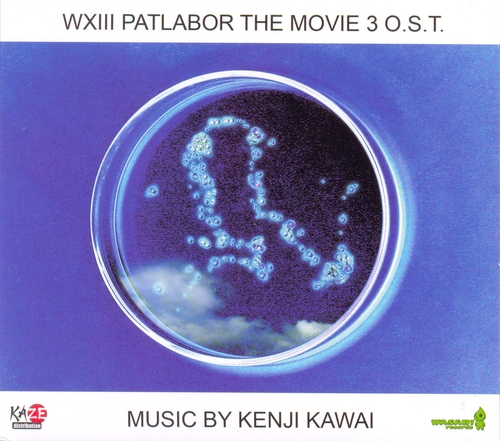
Couverture WXIII PATLABOR THE MOVIE 3 de Kenji KAWAI

Film japonais de 2002. Musique très ambient, et quelques plages avec des percussions très rêveuses.
- Takuji ENDO Réalisateur & réalisatrice
- Fumihiko TAKAYAMA Réalisateur & réalisatrice
- Kenji KAWAI Auteur de la musique
- 1 Title
- 2 Something beauty
- 3 Their daily lives
- 4 Inpatiants
- 5 Her solitude
- 6 Darkness besides airport
- 7 WXIII
- 8 At the institute
- 9 Invisible uneasiness
- 10 The self-defense forces
- 11 Detectives
- 12 The other side of her
- 13 Serious decision
- 14 Ryujin
- 15 Sonata für kalvier nr 8 pathetique Adagio cantabile / L.V. Beethoven
- 16 The last rain
- 17 Ending

Abonnez-vous à la newsletter Médiathèque Nouvelle
Nouvelles acquisitions, évènements, activités … Que vous soyez usager de la médiathèque ou professionnel de l'information, restez informé de toute notre actualité.